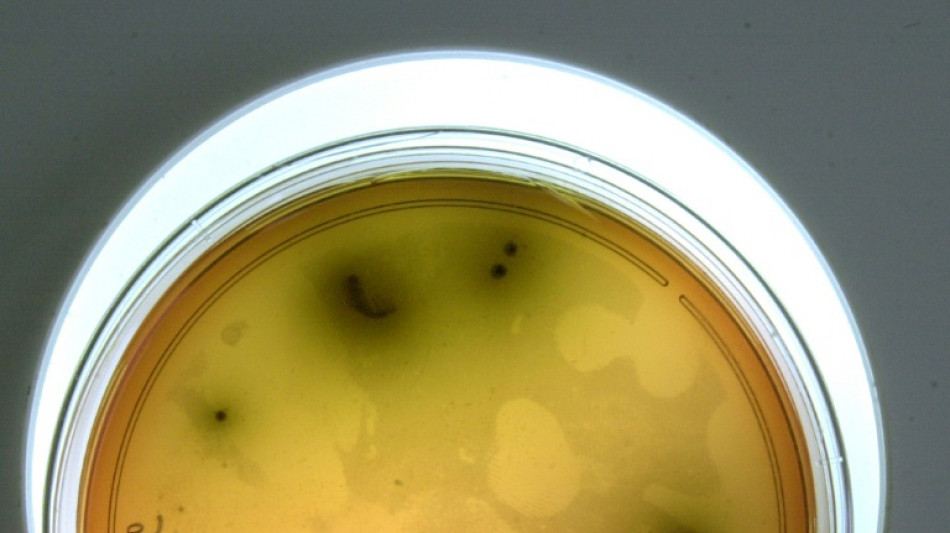
On comprend mieux comment la listeria peut gagner le cerveau

On comprend mieux comment la listeria peut gagner le cerveau
La listeria, bactérie à l'origine d'une infection alimentaire rare mais très dangereuse, parvient parfois à gagner le cerveau en rendant certaines cellules infectées résistantes au système immunitaire, avance une étude publiée mercredi.
Ce mécanisme "permet à ces cellules de survivre plus longtemps dans le sang et de passer en plus grand nombre dans le cerveau", résume ce travail, réalisé sur des animaux et publié dans la revue Nature.
La listeria est à l'origine de la listeriose. Cette infection alimentaire est rare - quelques centaines de cas par an en France - mais, une fois déclarée, elle est particulièrement meurtrière: environ un quart des patients décèdent.
Parmi les complications qui peuvent provoquer ces décès, figure la neurolistériose, c'est-à-dire une atteinte neurologique provoquée par le passage de la bactérie dans le système nerveux central, qui comprend le cerveau et la moelle épinière.
Réalisée en plusieurs étapes sur des souris de laboratoire, censées bien refléter l'évolution de la maladie chez l'humain, l'étude de Nature montre, dans un premier temps, que la listeria passe dans le cerveau via certains globules blancs, les monocytes.
Les chercheurs ont ensuite découvert comment ces cellules infectées gagnaient le cerveau sans être détruites par le système immunitaire. C'est une protéine présente dans la listeria qui semble les protéger.
Cette protéine, dite InlB, fait passer les cellules touchées sous le radar des lymphocytes T, dont le rôle est de détruire les cellules infectées par un virus où une bactérie.
Ce mécanisme "crée une niche de protection cellulaire qui encourage la dissémination et la persistance de la listeria" dans l'organisme, conclut l'étude.
Non seulement il permet à la listeria de passer dans le cerveau mais il lui laisse aussi le temps de survivre dans l'intestin et d'être présente dans les excréments. La bactérie peut donc être d'autant plus présente dans l'environnement et continuer à se propager ainsi.
Ce mode d'action est une surprise, de l'aveu des chercheurs, qui ne s'attendaient pas à ce que la listeria neutralise ainsi l'action des lymphocytes T.
C'est un "mécanisme spécifique et inattendu, par lequel un pathogène augmente la durée de vie des cellules qu’il infecte", résume le chercheur Marc Lecuit, qui a supervisé cette étude, dans un communiqué de l'Institut Pasteur, auquel sont rattachés plusieurs auteurs.
X.Badami--BD